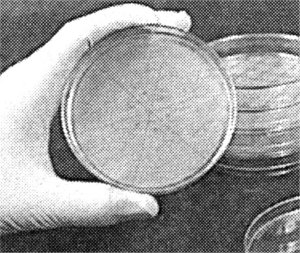

|
MATERIAIS
Precisará de microscópios,
máquinas capazes de remover e implantar organelos celulares, como
núcleos, de uma célula para outra. Precisa também de pratinhos
de laboratório e meios de cultura de tecidos. E, claro de células
humanas: da pele da pessoa que se deseja clonar e um ovócito.
PREPARAÇÃO:
1. As células da pessoa
a clonar têm de ficar algum tempo numa cultura nutritiva, para
que se multipliquem. Depois têm de ser mudadas para um outro meio
de cultura, que as deixa tão famintas que param de se dividir.
|
De
seguida, extrai-se-lhes o núcleo, onde se encontra o património
genético, que vai ser introduzido num ovócito. |
2. Esvazia-se um ovócito do seu núcleo...

... e introduz-se o núcleo da célula da pessoa a clonar.

 |
Aplica-se
uma descarga eléctrica para provocar a fusão do núcleo
transplantado com o ovócito. |
 |
|
Embrião
com cinco a seis dias |
|
|
|
células
estaminais |
|
|
|
|
|
|
|
5. Se o objectivo é
fazer clonagem terapêutica, o embriã6 é destruído, ao serem
colhidas as células estaminais que se podem transformar em todos
os órgãos e tecidos. De futuro, espera-se poder criar em laboratório
órgãos para transplantes.
6. Se o objectivo fosse
fazer nascer um bebé, o embrião seria implantado num útero,
para se desenvolver. A taxa de sucesso da clonagem de mamíferos
adultos, no entanto, é de apenas 1 por cento.

7. Com a tecnologia
actual, a maioria dos embriões ou fetos morrem durante a gestação,
com malformações, ou pouco depois do parto.

Mesmo os clones que
sobrevivem ao nascimento parecem ser mais velhos do que a sua
idade, porque foram criados a partir de células de indivíduos
adultos — como acontece com a ovelha Dolly, que além de obesa
tem artrite.
|